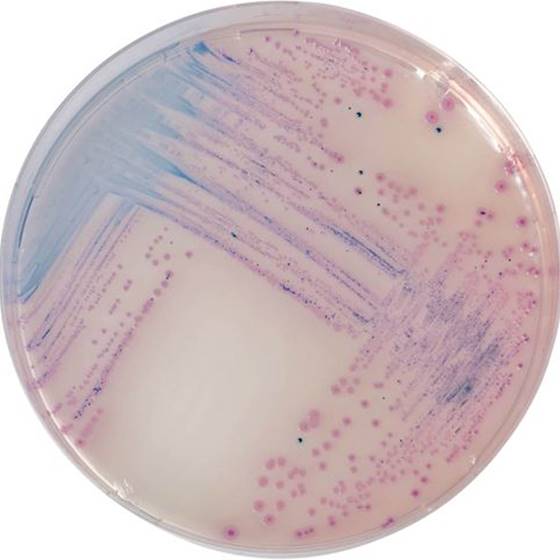

Über das Produkt
Chromogenes Medium zum Nachweis und zur Isolierung von Salmonella-Arten, einschließlich S. typhi und S. paratyphi in klinischen Proben.
CHROMagar Salmonella (5L)
Chromogenes Medium zum Nachweis und zur Isolierung von Salmonella-Arten, einschließlich S. typhi und S. paratyphi in klinischen Proben.